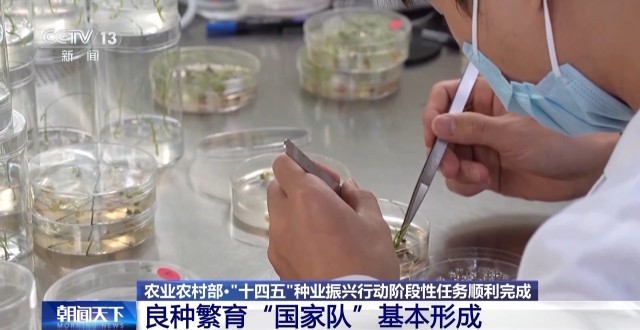

农业现代化,种子是基础。记者昨天(14日)从农业农村部了解到,“十四五”时期,我国启动种业振兴行动,目前,阶段性任务顺利完成。
“十四五”时期,农业种质资源“家底”更加厚实。我国完成新中国成立以来规模最大、覆盖范围最广的全国农业种质资源普查,摸清了资源家底,并建成国际一流的农作物、畜禽、海洋渔业三大国家种质库,资源保存总量跃居世界第一。

“十四五”时期,种业科技创新整体进入世界第一方阵。培育出高抗赤霉病小麦、抗稻飞虱水稻、耐密宜机收玉米、耐除草剂高油高产大豆等一批重大新品种。
“十四五”时期,种业基地供种能力明显增强。以甘肃玉米、四川水稻、黑龙江大豆、海南南繁四大国家级育制种基地为核心的良种繁育“国家队”基本形成。目前,国家级种业基地供种保障率达到80%,比2020年提高10个百分点。

种业振兴行动启动五年来,目前我国种源安全水平稳步提升,农作物自主选育品种占比95%以上,畜禽、水产国产种源市场占有率分别超过80%和85%。农业用种安全总体有保障、风险可管控的态势更加牢固。